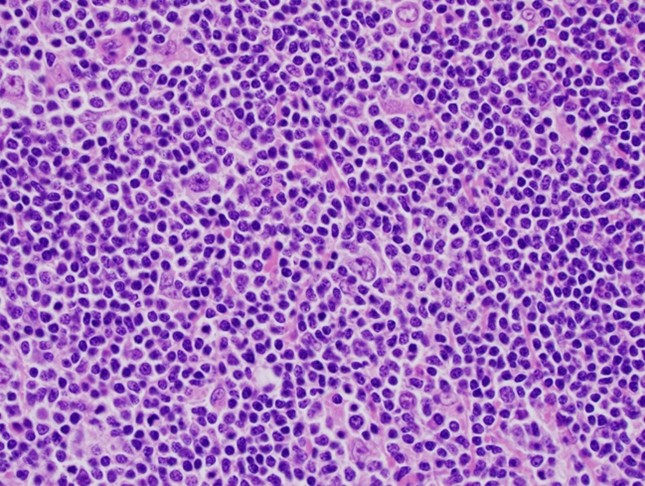

Author: Wakenda K. Tyler, MD and Vikranth Mirle, MD
Description
Lymphoma is a type of cancer that starts in lymphocytes, which are white blood cells that normally help the body fight infections. There are two main types of lymphoma – Hodgkin lymphoma and non-Hodgkin lymphoma. Both types can involve the lymph nodes, organs, or bone. Hodgkin lymphoma is most common in young adults (around age 25) and later in life ( around ages 75-80). Non-Hodgkin lymphoma is more common overall, usually developing later in life, and it happens more often in men.
Symptoms
Swollen lymph nodes (small glands in the neck, armpit, or groin that help the body fight infection) that are not painful are common in lymphoma. Some people may also have what doctors call “B symptoms,” which include fevers, chills, night sweats, or weight loss. If the lymphoma spreads to the bone, it can cause ongoing bone pain (sometimes worse at night) or even broken bones after only a small injury or walking. Non-Hodgkin lymphoma is more likely than Hodgkin lymphoma to affect the bones and cause these types of breaks, called “pathologic fractures.
On physical exam, doctors may find enlarged lymph nodes that are not painful. If the bones are affected, there may be tenderness or pain in those areas. Some patients also show signs of general illness, such as fever or weight loss.
Tests
Testing usually includes blood tests to check blood counts and how the organs are working. Imaging such as X-rays or MRI (magnetic resonance imaging) may be used to see if the bones are involved. A PET/CT scan (a special test that combines pictures of the body with information about how active the cancer cells are) can help show where the lymphoma is present. The most important step is a biopsy, where a small piece of tissue is removed and examined under the microscope with special stains to confirm the diagnosis.
Images
Figure 1: X-rays may demonstrate poorly defined areas of bone loss, appearing “moth-eaten” or mottled.

Figure 2: Microscopic view of Hodgkin lymphoma biopsy tissue.
Prognosis
Treatment may include chemotherapy, radiation, and sometimes surgery to repair or strengthen affected bones. Hodgkin lymphoma has a very good outlook, with cure rates of about 90% when found and treated early. Non-Hodgkin lymphoma has a wider range of outcomes depending on the type. Some forms grow slowly and are harder to cure, while others grow more quickly but often respond well to treatment. It is important to see an Orthopedic Oncologist (a bone cancer specialist) if the bones are affected, so they can help guide treatment and protect bone strength.
More Information
Lymphoma Research Foundation - https://lymphoma.org/
American Society of Hematology - https://www.hematology.org/education/patients/blood-cancers/lymphoma
American Cancer Society - https://www.cancer.org/cancer/types/lymphoma.html
Primary Lymphoma of Bone, Orthoinfo - https://orthoinfo.aaos.org/en/diseases--conditions/primary-lymphoma-of-bone
This is not intended as a substitute for professional medical advice and does not provide advice on treatments or conditions for individual patients. All health and treatment decisions must be made in consultation with your physician(s), utilizing your specific medical information. Inclusion in this is not a recommendation of any product, treatment, physician or hospital.


